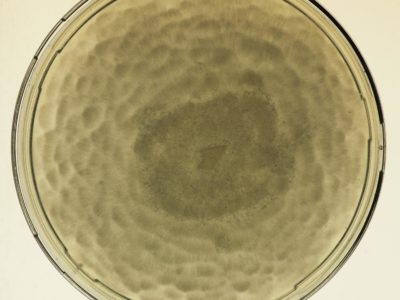

Research projects
Filter:
Showing: All projects
253 projects

POLOMINTS
The overarching goal of POLOMINTS is to determine the key mechanisms of internal tsunamigenesis across a wide range of temporal/spatial scales of glacier calving and ocean conditions, and to quantify …

BIOPOLE
Overview Climate change is proceeding faster at the poles than any other region, with sea-ice retreating, glaciers melting and biotic communities being invaded by sub-polar species. These changes are affecting …

DEFIANT
Overview While climate models suggest Antarctic sea ice extent should also reduce in response to rising atmospheric CO2 concentraions, satellite observations reveal that during 1979-2015 the opposite was in fact …

International Thwaites Glacier Collaboration
This joint UK-US research programme aims to improve the understanding of the processes affecting ice sheet stability to predict, with more certainty, the future impact of sea-level rise from Thwaites …

KANG-GLAC
The Greenland Ice Sheet is decaying at an accelerating rate in response to climate change. Warm ocean waters moving through the fjords eventually meet the faces of marine-terminating glaciers, increasing …

MesoS2D
In order to accurately predict impacts of space weather and climate variability on the whole atmosphere we need an accurate representation of the whole atmosphere. The mesosphere (~50-95 km altitude) …

OCEAN:ICE
Overview OCEAN:ICE will assess the impacts of key Antarctic Ice Sheet and Southern Ocean processes on Planet Earth, via their influence on sea level rise, deep water formation, ocean circulation …

Southern Ocean Clouds
SOC is a project of the NERC CloudSense Programme The biases observed in climate models over the Southern Ocean in surface radiation and sea surface temperature are larger than anywhere …

SURFEIT
Surface Fluxes in Antarctica (SURFEIT) is a BAS National Capability International research programme. Its primary aims are to bring together relevant members of the international scientific community and increase our …

SWIMMR-T
Space debris is emerging as a key problem for humanity with the potential to cause major socio-economic impacts. It is currently estimated that there are over 900,000 pieces of debris …

The Big Thaw
The Big Thaw is an ambitious new UKRI/NERC-funded Highlight Topic project assessing past, present and future changes in global mountain water resources by studying snow/ice accumulation and melt in the …

‘Sounds of Space’
Using a Very Low Frequency receiver at Halley Research Station we can pick up radio waves made by our planet. We use these waves to investigate the science of space …

60 Second Science
We’ve challenged our science, engineering and support staff and their research collaborators to explain in 60 seconds what they do. Decide for yourself if they have met the challenge well! …

A High-Order Model of the Earth’s External and Induced Magnetic Field
For centuries people have used magnetic compasses to guide them on their way and explore new territories. This has led scientists to embark on their own journeys of discovery about …

A new polar research ship for Britain: project delivery
A new research platform to put UK scientists at the forefront of polar science

A23 repeat section
Understanding Antarctic Bottom Water (AABW) and its affect on global ocean circulation.

ABSCISSA
The source of sea-salt aerosols in the Polar Regions appears to be linked to sea ice surfaces, but exact details are unclear. Defining the sources is important given the critical …

ACSIS
Major changes are occurring across the North Atlantic climate system: in the ocean and atmosphere temperatures and circulation, in sea ice thickness and extent, and in key atmospheric constituents such …

AI for Earth Observation
Recent increases in the spatial coverage and temporal resolution of 40 m resolution Synthetic Aperture Radar (SAR) imagery, is opening new opportunities to rapidly detect environmental observations e.g. ice sheet and iceberg position with greater positional accuracy. Our team are developing supervised and unsupervised machine learning techniques to automatically detect sea ice and iceberg position from Sentinel-1 SAR imagery.

AI for smart conservation
In the AI for smart conservation project, BAS are collaborating with local ecologists and conservation agencies to develop decision-making tools informed by sea ice forecasts. By combining satellite observations, GPS …

AI4EOAccelerator
The AI4EO Accelerator is a collaboration between Φ-Lab of the European Space Agency (ESA) and the UKRI Centre for Doctoral Training (CDT) in the Application of Artificial Intelligence to the …

ANGWIN
ANGWIN is now a SCAR action group. See the proposal that was presented at the Polar 2018 conference here: SCAR_Proposal.pdf ANGWIN (in the Cornish English dialect ANGWIN means “the white”) …

ANiSEED
This project will reconstruct millennial-scale ice sheet change in the western Amundsen Sea Embayment, Antarctica, using high-precision exposure dating.

Antarctic Climate over the last millennia
The Antarctic Peninsula and West Antarctica have warmed dramatically in recent decades, with some climate records indicating that these are among the most rapidly warming regions on Earth. The Antarctic …

Antarctic Coastal Winds
Winds along the Antarctic coast are small scale but have global importance. Climate models must have a realistic representation of these winds as they influence ice shelves, sea ice and …

Antarctic Digital Database
The SCAR ADD is a seamless compilation of topographic data for Antarctica to 60°S. It is the place to go to get data such as Antarctic coastline or contours for working in desktop GIS.

ApRES and groundwater
The aim of this study is to investigate whether a technique developed to measure the basal meltrate of ice shelves can be used to monitor groundwater in arid and semi-arid …

Arctic marine geophysics
This research focuses on investigating the glacial histories of Arctic ice sheets and ice caps using the marine geological record preserved on continental margins. By reconstructing past ice sheets, their …

Arctic PASSION
The Arctic is more affected by climate warming than any other region. To monitor the ongoing changes, to predict the evolution of the climate system and to develop mitigation measures, …

Arctic Summer-time Cyclones
The Arctic Summer-time Cyclone Project is a joint project of scientists from the University of Reading, University of East Anglia and the British Antarctic Survey with expertise in atmospheric dynamics, …

ASCCC
The ASCCC Project has been funded by ACE (Antarctic Circumnavigation Expedition) to investigate, quantify and understand the role of polar and subpolar seabeds in the carbon cycle, particularly in response …

Ascension Island Marine Sustainability (AIMS)
The project Ascension Island Marine Sustainability (AIMS) – A Fisheries and Marine Biodiversity Project Ascension Island harbours globally important marine biodiversity, potentially representing a unique assemblage of western and eastern …

Atmospheric Data Access System
An online data access tool to discover, visualise and access atmospheric and space weather data holdings from the polar regions.

Automated lithological mapping using airborne hyperspectral remote sensing
Antarctica is a unique and geographically remote environment. Field campaigns in the region encounter numerous challenges including the harsh polar climate, steep topography, and high infrastructure costs. Additionally, field campaigns …

AWERB
The BAS Animal Welfare & Ethics Review Body (AWERB) enforces British Antarctic Survey’s duty of care to protect animals. The AWERB review each and every application, from any project that …

BAS-RBM
The radiation belts are the region of space around the Earth where high energy charged particles are trapped by the Earth’s magnetic field. The energy of the particles and their …

BBAS
The BBAS science programme was a British Antarctic Survey-funded project, part of the wider BBAS-AGASEA collaboration between BAS, the University of Texas Institute for Geophysics (UTIG), and the U.S. National …

BEAMISH: Basal Conditions on Rutford Ice Stream
The polar ice sheets play a major role in controlling Earth’s sea level and climate, but our understanding of their history and motion is poor. The biggest uncertainty in predicting …

Bedmap
Bedmap is a collaborative community project with the aim to produce a new map and datasets of Antarctic ice thickness and bed topography for the international glaciology and geophysical community, …

Bedmap Himalayas
Bedmap Himalayas is an ongoing BAS core-funded and grant-funded programme. It aims to measure how much water much is stored as glacier ice in High Mountain Asia. In warm weather, …

Bedmap2
understanding whats beneath the ice, opens new opportunities for detailed modelling of the past and future evolution of the Antarctic ice sheets

Bedmap3
Bedmap3 is a collaborative community project with the aim to produce a new map and datasets of Antarctic ice thickness and bed topography for the international glaciology and geophysical community, …

Beyond Epica
A decade ago, the European EPICA project completed drilling a deep ice core at Dome C, revealing the close link between climate and atmospheric greenhouse gases over the past 800,000 …

BID
The BAS Transformation Programme is a key driver of change across the organisation. Our ambition is to pull together our in-house expertise to rethink our future ways of working. In …

Biodiversity at BAS Cambridge
Biodiversity@BAS is an initiative formed by BAS staff. Adopting current NERC Biodiversity policy and working closely with BAS Estates and Environment Office teams, its goal is to assist with the …

Black-browed Albatross Juvenile Tracking
Until the last decade, South Georgia held the third largest population of black-browed albatrosses at any island group (Phillips et al. 2016) [4]. However, assuming trends at surveyed sites are …

British Antarctic Oral History Project
Capturing the reminiscences and memories of those involved in British polar science

Brunt Ice Shelf movement
British Antarctic Survey is monitoring cracks on the Brunt Ice Shelf. Find out how here

Building data resources for managing the South Georgia & South Sandwich Islands Marine Protected Area
The South Georgia and South Sandwich Islands (SGSSI) Marine Protected Area (MPA) was established by the Government of South Georgia and the South Sandwich Islands in 2012, to ensure the …

Bycatch risk of wandering albatrosses from radar detection
Wandering albatrosses are threatened by bycatch. Populations at South Georgia have declined catastrophically since the 1960s due to incidental mortality (bycatch) in fisheries (Pardo et al. 2017) [1]. This led …

Cambridge Centre for Climate Science
CCfCS promotes interdisciplinary research in climate science across the wide range of departments and institutes in Cambridge.

CANARI
Extreme weather events can have substantial impacts. For instance: the extensive UK flooding during the stormy winters of 2013/14 and 2015/16 resulted in £3 billion of damage to property and …

Changing biodiversity
Baseline study to monitor how marine biodiversity will respond to climate change

Chinstrap Penguin Tracking
The commercial fishery for Antarctic krill (Euphausia superba) operates in the southwest Atlantic, in particular along the west Antarctic Peninsula, and over the shelf breaks of the South Shetland Islands, …

Climate and Ice during the Last Interglacial
During the Last Interglacial (129-116 thousand years ago, ka) CO2 and global temperature were both higher than they were before human industrialisation. By examining Last Interglacial climate, we thus gain …

Climate Code
This collaborative project is born from exploring novel ways of visualising environmental data and telling the climate change story. Read more about the project and the science behind it through the project page.

Cold Skeletons
Does the cold affect how animals grow? Are skeletons different in Antarctic marine species, which survive almost permanently below 0°C? It is well known that animals grow at different rates …

COMICS
Investigating the twilight zone The four-year COMICS project, is led by the National Oceanography Centre, is a collaboration between the British Antarctic Survey and the universities of Queen Mary London, …

CONSEC
CONSEC is addressing the challenge to understand the links between the biodiversity, structure and function of Southern Ocean ecosystems and the impacts of rapid environmental changes to improve scientific knowledge …

Continuous Plankton Recorder
Contemporary research has shown that the Southern Ocean is warming. Summer surface temperatures have risen by more than 1 degree Centigrade in the last 80 years and a strong upper-layer …

CRiceS
Sea ice is an integral, changing part of the global Earth system. The polar climate system affects lives and livelihoods across the world by regulating climate and weather; providing ecosystem …

CUPIDO
CUPIDO aims to address: what is the role of zooplankton in promoting the transport of plastic in the ocean?
and how this plastic transport interferes with zooplankton’s ability to store carbon in the deep ocean?

Darwin Plus SO Red Listing
The IUCN Red List is the international standard for conservation, a crucial tool to communicate threats to species, which can be applied to all species and ecosystems. Molluscs represent a …

Data As Art
DATA AS ART is an ongoing science & art project in development at NERC’s British Antarctic Survey (BAS). It visualises science data (in its widest definition), to create stunning and …

Depositional patterns and records in sediment drifts off the Antarctic Peninsula and West Antarctica
The biggest uncertainty in predictions of sea-level rise is what the contribution will be from the great ice sheets on Antarctica and Greenland as climate warms. The West Antarctic Ice …

Detecting rare earth elements with remote sensing
Rare earth elements (REEs) are a group of naturally occurring, chemically similar elements present in the Earth’s crust. Over the past decades these elements have become increasingly critical to many …

DI4EDS
Environmental research relies on digital infrastructure (hardware, software and methods) to provide services that help researchers answer questions about the environment around us, and innovators to work out ways that …

Digital Twins of the Polar Regions
Digital Twinning is next generation technology for data fusion and computer modelling enabling us to rapidly get answers to “what-if” questions. Digital Twins (DTs) are already in operation in industry …

Discovery Metadata System
A web-based system to discover polar datasets collected by UK-funded scientists
Diversity in UK Polar Science Initiative
Foreign, Commonwealth & Development Office helping increasing representation of people from under-represented groups engaged in Polar Science.

DRAGON-WEX
DRAGON-WEX (the DRake pAssaGe and sOuthern oceaN – Wave EXperiment) is a NERC funded standard grant between the University of Bath and the British Antarctic Survey. We will implement and …

DRIIVE
DRIIVE will use the new EISCAT_3D radar to understand multi-scale coupling in the Ionopshere and how it is influenced both by space weather and the lower atmosphere. The impact of …

Dynamic Live Cell Imaging
Dynamic live cell imaging at sub-zero temperatures How do Antarctic marine organisms, such as fish, manage to thrive at temperatures below 0°C? How do their cells and in particular, their …

DynOPO
Dynamics of the Orkney Passage Outflow (DynOPO) is a collaboration between BAS, the University of Southampton and the National Oceanography Centre (NOC). The project aims to investigate the flow of …

EC Copernicus Marine Environment Monitoring Service
The Copernicus marine environment monitoring service provides regular and systematic reference information on the state of the physical oceans and regional seas. The observations and forecasts produced by the service …

EISCAT Science Support
The UK EISCAT support group (UKESG) is a collaboration between the British Antarctic Survey and the Rutherford Appleton Laboratory, funded via the National Centre for Atmospheric Science (NCAS) EISCAT, the …

Electron Acceleration in the Radiation Belts of Earth, Jupiter & Saturn
Radiation belts of very high energy electrons and protons can form around some planets – at the Earth these large donut shaped regions in space are often called the Van …

Evaluating climate change risks to Patagonian and Antarctic toothfish
This is a Darwin Plus project, funded by Defra, and its activities are focussed in the UK Overseas Territory (OT) of South Georgia & the South Sandwich Islands. The project …

ExtAnt
ExtAnt started in February 2024 and is a 4 year NERC Highlight Topic project. Work is around three research aims (RAs): RA1. Quantify the relative contributions of key drivers of …

Filchner Ice Shelf System, Antarctica
Understanding the contribution that polar ice sheets make to global sea-level rise is recognised internationally as urgent. The mission of this five-year project is to capture new observations and data …

Fish by-catch in the Antarctic krill fishery
Fish bycatch is a global problem requiring accurate information to develop conservation and management strategies. Within the Antarctic krill fishery, fish and larval fish are regularly observed as bycatch. Improved …

Fixed wing wildlife surveys at South Georgia
At South Georgia, the climate is changing. Further, species abundances are changing with the recovery of historically depleted species of seal, whale and finfish. In addition, the eradication of introduced …

Gentoo Penguin Tracking
A fishery for Antarctic krill (Euphausia superba) operates over the shelf breaks of the South Orkney, South Shetland and South Georgia archipelagos [8]. Krill is an important food source for …

Geological Collection
Contains over 200,000 individual rock and fossil specimens collected from Antarctica and the sub-Antarctic islands and thousands of meters of sediment core from the surrounding seabed.

Geological History Constraints on the Magnitude of Grounding Line Retreat in the Thwaites Glacier System
GHC (“Geological History Constraints”) will gather information about past ice sheet behaviour and relative sea level change in the Thwaites Glacier system. Determining the timing and magniture of past episodes …

Geological mapping of British Antarctic Territory
Geological maps remain the most effective method of communicating large amounts of geological information. An ongoing project to compile over 50 years of geological field data into new geological maps …

Geophysical Habitat of Subglacial Thwaites
GHOST is an ice-based project which will examine the bed beneath the Thwaites Glacier, to assess whether conditions are likely to allow rapid retreat, or if the retreat may slow …

GOCE+Antarctica
GOCE+Antarctica- Dynamic Antarctic Lithosphere -is an international project supported by the European Space Agency (ESA) that is using GOCE satellite gravity gradient data, GPS data and innovative 3D modelling to …

GRADES-IMAGE
The GRADES-IMAGE science programme was a British Antarctic Survey-funded project over the Antarctic Peninsula and Filchner-Ronne Ice Shelf. The aim of the programme was to image englacial layering and bedrock …

Grey-headed Albatross Juvenile Tracking
The grey-headed albatross is listed as Endangered in the IUCN Red List of Threatened Species because of a decline since the 1970s of the largest global breeding population, which is …

Halley Automation
Halley Automation This innovative, multi-year, project aims to provide a micro-turbine power supply and datalink to a suite of autonomous scientific instrumentation around the Halley VI Research Station and on …

Halley Research Station relocation
In 2017 Antarctica’s first re-locatable research station was moved successfully 23 km inland to avoid the path of large cracks in the ice

Herbarium Collection
A collection of dried plant specimens from the Antarctic, sub-Antarctic and surrounding continents.

HEXPLORES
The HEXPLORES project aims to explore for active hydrothermal vents in the Red Sea Rift. Although the Red Sea Rift hosts the world’s largest submarine metalliferous sulphide deposit, no active …

Higher Predators – Long-Term Science
The British Antarctic Survey carries out Long Term Science that measures changes in Antarctic ecosystems and seeks to understand the underlying drivers and processes. Marine predators are sensitive to changes …

HOTRAY Ray Tracing Model
HOTRAY is a ray tracing computer code designed to trace the path of electromagnetic waves in a hot magnetised plasma. HOTRAY has been used to understand the generation and propagation …

Hungry Humpbacks
Whales are the largest krill predators in the UK Overseas territory of South Georgia, yet their impacts on krill stocks are poorly understood. Recently, whale surveys revealed high summer abundance …

Ice Sheet Modelling
The research of the ice sheet modelling group focuses on integrating observational data with dynamical models that describe how the ice flows in order to improve our representation of how …

ICE-ARC
physicists, chemists, biologists, economists, and sociologists from 21 institutes in 11 countries across Europe assess the rapid retreat and collapse of Arctic sea-ice cover

IceAGE
The international IceAGE (Icelandic marine Animals: Genetics and Ecology) project, initiated in 2008 and managed by Drs Saskia Brix and Karin Meißner from DZMB Hamburg, Germany, builds on data obtainedby …

ICED
ICED is an international multidisciplinary programme launched in response to the increasing need to develop integrated circumpolar analyses of Southern Ocean climate and ecosystem dynamics. ICED has been developed in …

ICEGRAV
The ICEGRAV project is a major international collaboration between Danish, US, UK, Norwegian and Argentinian scientists. The primary aim of the project is to carry our airborne gravity observations across …

Iceland Greenland seas Project
PI: Ian Renfrew (University of East Anglia) CO-I’s: Tom Bracegirdle, Tom Lachlan-Cope, Alexandra Weiss PDRA’s: Andrew Elvidge (University of East Anglia), James Pope NERC Grant: NE/N009924/1 Project Partners: Robert Pickart …

IceNet
IceNet is a probabilistic, deep learning sea ice forecasting system developed by an international team and led by British Antarctic Survey and The Alan Turing Institute [Andersson et al., 2021]. …

Identification of glacial-time sources for Antarctic deep- and bottom-water masses
Over the past few millions of years, the Earth’s climate has switched between (cold) glacial and (warm) interglacial states many times. Although driven by long term changes in the Earth’s …

IMAGE Auroral Boundary Data
The objective of this project was to investigate whether magnetic reconnection in the space environment has a characteristic scale in space and time by characterising statistically the spatial and temporal …

IMCONet
IMCONet is an international Research Network that follows an interdisciplinary approach to understand the consequences of Climate Change in coastal Western Antarctica. A Network for Staff Exchange and Training, IMCONet …

Impact of global disturbances on evolution of polar life
Why does global biodiversity show such a steep increase just as climates were deteriorating?

Impact of Melt on Ice Shelf Dynamics and Stability (MIDAS)
Project MIDAS (Impact of Melt on Ice Shelf Dynamics And Stability) is a UK-based Antarctic research project, investigating the effects of a warming climate on the Larsen C ice shelf …

Impact of Plastic in the Polar Regions
An estimated 75% of all the litter in our oceans is plastic, and around 5 million tonnes of plastic waste enter the ocean annually. Scientific observations of a significant concentration …

Impact of Southern Westerly Winds and Circumpolar Deep Water on climate and marine ecology
The Antarctic Peninsula has warmed ~3°C over the last 50 years, approximately 6 times faster than the global average. Mechanisms for this accelerated rate of warming have been linked with …

Impacts of Ocean Acidification on Sea-Surface
In order to assess the impact of anthropogenic carbon dioxide (CO2) on the oceans today we are investigating the effect of decreasing upper ocean pH on calcifying zooplankton. Pteropods, …

Improving estimates of Antarctica’s contribution to sea level
This research aims to improve estimates of Antarctica’s contribution to sea level. Sea level is currently rising at approximately 3mm/yr. If we are to understand why it is rising and …

ISOL-ICE
PI: Markus M. Frey Co-I’s: X. Yang, R. Mulvaney NERC Grant: NE/N011813/1 The ozone layer shields all land-based life forms from harmful ultraviolet radiation; and indirectly influences the climate at …

iSTAR – Stability of the West Antarctic Ice Sheet
Science on the move – the mission to understand the stability of the West Antarctic Ice Sheet

iSTAR-A Ocean2Ice Processes and variability
iStar-B strives to better understand ocean and ice interaction, processes and variability

iSTAR-B Ocean circulation and melting beneath the ice shelves of the south-eastern Amundsen Sea
iStar-B studies ocean circulation and melting beneath the ice shelves of the south-eastern Amundsen Sea

iSTAR-C Dynamical control on the response of Pine Island Glacier
iStar-C – strives to understand the dynamical control and response to change of Pine Island Glacier

iStar-D The contribution to sea-level rise from the Amundsen Sea sector of Antarctica
iStar-D will identify the potential contribution to sea-level rise, from ice locked in the Amundsen Sea sector of Antarctica

Joint Airborne Study of the Peninsula Region (JASPER)
JASPER brings together two of the best equipped Polar meteorology instrumented aircraft and teams to study boundary layer meteorology in the Antarctic Peninsula and Weddell Sea. A joint project between …

Joule Heating
Society is highly dependent on the fleet of satellites that surround our planet. We rely on them for entertainment, communication, navigation, weather forecasting, and more. Many day-to-day activities, such as …

King Edward Point Research Station Modernisation
New mooring and boating facilities for South Georgia’s fisheries research station

Krill Hotspots
Antarctic krill (Euphausia superba) are a key component of the food chain throughout much of the Southern Ocean. These small, shrimp-like animals occur in dense swarms, but their distribution is …

KRILLBASE
KRILLBASE is a data rescue and compilation project which aims to improve the availability of information on two of the Southern Ocean’s most important zooplankton taxa: Antarctic krill (Euphausia superba) …

Larsen-C Benthos
On 12 July 2017, the Larsen-C Ice Shelf calved one of the largest iceberg originating from the Antarctic Peninsula ever recorded. As iceberg A68 moves north, it leaves behind an …

Late Quaternary changes in the Westerly Winds over the Southern Ocean
In this NERC-funded project, we are generating Southern Hemisphere Westerlies (SHW) proxy records from each of the three major sectors of the Southern Ocean, focusing on subantarctic islands situated in …

Long term monitoring of plastics
This long-term study monitors the impact of marine plastics and other debris on breeding seabirds at Bird Island. Researchers have monitored the levels of marine plastics and other material from …

Marine Metadata Project
The Marine Metadata Project aims to enhance the availability and accessibility of BAS marine data.

Melting at Thwaites Grounding Zone and its Control on Sea Level
MELT is an ice-based project that will use autonomous sensors to monitor the ice column and ocean beneath the ice shelf in the critical area of the grounding line (the …

Meteorology and Ozone Monitoring
Long-term meteorological and ozone observations and data help determine the causes of climate change in the polar regions. Meteorology Meteorological observations are made regularly throughout the day at Halley and …

Methane Observations and Yearly Assessments
Methane is one of the most important greenhouse gases in the atmosphere, and changes in its concentration could have major influences on the Earth’s climate. Measurements made around the world …

Microphysics of Antarctic Clouds NE
Introduction and Background The largest uncertainties in future climate predictions highlighted by the Intergovernmental Panel on Climate change (IPCC 2007) arise from our lack of knowledge of the interaction of …

Modelling Movement of Antarctic Krill
The MMAK project is using state-of-the-art ocean-sea ice models to improve our understanding of processes that influence the distribution of krill in the South Orkney Islands region.

Monitoring climate change in action
Long term science We know that our world is changing due to human influence. But how is it changing? Some areas, such as the Antarctic Peninsula, are changing more rapidly …

NERC Arctic Office
The NERC Arctic Office, at BAS, manages the UK Arctic Research Station at Ny-Ålesund on Svalbard and is closely linked to the NERC Arctic Research Programme

North Sea Methane
Offshore gas fields worldwide are major sources of methane emissions. Developing reliable methods to locate emissions and pinpoint sources is critical for quantifying the volume of methane emissions from gas …

Ocean-driven ice-shelf thinning in Antarctica
By exploiting advances in ice sheet modelling, and new Antarctic-wide datasets, this project aims to predict how far and how fast the observed ocean-driven thinning of floating ice shelves will …

Oceanographic models for the Scotia Sea
Development of regional models to examine the detailed oceanography of island shelves and surrounding regions.

ORCHESTRA
Understanding the Ocean Regulation of Climate by Heat, Carbon Sequestration and Transports

Orkney Passage Long Term Monitoring
The densest waters in the Atlantic overturning circulation, Antarctic Bottom Water (AABW), originate in the Weddell Sea, as Weddell Sea Deep Water. A large proportion is exported northward to the …

Orographic Flows and the Climate of the Antarctic Peninsula (OFCAP)
OFCAP is an integrated programme of field observations, analysis and modelling aimed at understanding how the westerly winds in the Antarctic Peninsula interact with the mountains and influence the climate …

P-RAID
The ice sheets of Antarctica can be several kilometres thick, and contain precious information about the past climate. However, the bottoms of the ice sheets are melting, erasing this information. …

PADIE
Recent research has demonstrated that electro-magnetic waves present in space can have a dramatic effect on the charged particles in the radiation belts. Under certain conditions the particles can resonate …

Paleogene Climate and Deep-water Evolution in the Southwest Atlantic
This project will tackle the the question of how strongly changes in ocean circulation affect global climate. The study is being carried out in collaboration with Dr Steve Bohaty and …

ParaKrill
Krill are essential components of Antarctic ecosystems – they are important prey for fish, seals, penguins, and whales, and they influence carbon and nutrient cycling. This keystone role of krill …

Past Westerly Winds
The behaviour of the westerly wind belt (see Figure 1a) over the Southern Ocean during cold glacial periods has been debated for many years. These winds matter because explanations of …

Penguin foraging in a warming ocean
The aim of this project is to learn more about the feeding habits of penguins around the Antarctic Peninsula to understand how their behaviour may be changing as the waters …

POETS-WCB
The main deliverable of the Western Core Box (WCB) is a consistent unique time series of mesoscale distribution and abundance of macro-zooplankton and micronekton, and an understanding of the physical …

Polar Airborne Geophysics Data Portal
The NERC Airborne Geophysics Data Portal provides direct access to airborne survey data.

Polar Ice
The aim of this project is to develop a next generation sea ice information service by integrating and building on a wide range of European and national funded activities which …

Polar Thematic Exploitation Platform
A Polar Thematic Exploitation Platform (Polar TEP) is being developed for the European Space Agency (ESA). Polar TEP will provide polar researchers with access to computing resources, earth observation (EO) …

Polar View
Polar View delivers information about sea ice direct to ships operating in the Southern Ocean.

PolarGAP
The polar regions have the capacity to amaze and astound, but despite the considerable progress of recent decades we still know far less about them than less remote parts of …

PolarRES
The Polar regions play a crucial role in balancing the global climate system – with the poles heating up much faster than the rest of the world. Yet, climate projections …

Port Lockroy Data Portal
Port Lockroy is the site of the first permanent British Antarctic base, ‘Base A’. This historic station was designated Historic Site No. 61 under the Antarctic Treaty on the 19th …

PRESCIENT
PRESCIENT (UK Polar Research Expertise for Science and Society) is a joint programme between BAS (British Antarctic Survey) and CPOM (the Centre for Polar Observation and Modelling). The programme supports …

Protecting Marine Ecosystems in the South Atlantic
The food security and economies of Tristan da Cunha and St Helena, British overseas territories in the South Atlantic, are heavily reliant on marine harvestable resources and, to a lesser …

QEPPA
QEPPA is a joint project between the British Antarctic Survey and the Space physics group at Lancaster University. The objective of QEPPA is to work out the amount of charged …

Rad-Sat
Rad-Sat is a NERC Highlight Topic that brings together a consortium of scientists from 5 different UK research groups, stakeholders from the space industry and a network of international collaborators. …

Radbelt-DA
The goal of the Radbelt-DA project is to apply data assimilation techniques used in weather forecasting to the BAS radiation belt model (BAS-RBM). This will enable much better reconstructions of …

RAID
Ice cores take a long time to collect. The 3.4 km- ice core drilled at Dome Concordia (Antarctica) took 5 years to collect and encloses the oldest ice drilled so …

RAPIDKRILL
Even though the majority of measures to manage the marine environment are relatively fixed or adhere to set formulas (e.g. marine protected areas, total allowable catches and quota setting), the …

READER
READER (REference Antarctic Data for Environmental Research) is a project of the Scientific Committee on Antarctic Research (SCAR http://www.scar.org/) and has the goal of creating a high quality, long term dataset …

Real Projections
Predicting how the climate will change as human activities lead to emission of more greenhouse gases is a global scientific challenge for climate scientists. We use models of the climate …

Renewable Energy within AIMP
The British Antarctic Survey (BAS) operates in the most remote places on earth including the Antarctic, the Southern Ocean and the Arctic. The challenges around logistics and extreme weather conditions …

Resisting temperature change in the marine environment
Can animals used to living in freezing waters cope with climate change? Will they survive in a warmer world? Marine animals around Antarctica are very used to living in water …

RIFT-TIP
RIFT-TIP is a NERC-funded scientific project investigating iceberg calving and fracture growth in ice shelves. The RIFT-TIP team will work primarily out of Halley Research Station, using seismic, radar, ApRES …

Role of oceanic forcing in West Antarctic Ice Sheet retreat
Ocean temperature has been identified as a key driver of current ice sheet retreat in the Amundsen Sea sector of the West Antarctic Ice Sheet (WAIS), yet its long-term history …

Rothera Research Station Modernisation
Over the next decade Rothera Research Station will be upgraded to ensure its facilities keep the UK at the forefront of climate, biodiversity and ocean research.

Safeguarding Antarctic krill stocks for baleen whales
This Darwin Plus funded project aims to improve our understanding of how Antarctic krill, foraging whales and the krill fishery interact in space and time, to improve krill fishery management …

Sat Risk
Sat-Risk – Satellite Radiation Risk Forecasts – is a collaborative project between several academic institutions and stakeholders. The project is part of the Space Weather Instrumentation, Measurement, Modelling and Risk …

Scalable automated detection and tracking of icebergs in the Southern Ocean
We are developing fully automatable methods for the detection of icebergs using satellite radar data and bayesian tracking methods to monitor icebergs at the individual level and continental extent.

Science-Policy Challenges in Polar Conservation and Management
The British Antarctic Survey and the Cambridge Conservation Initiative (CCI) are convening a series of half day workshops focused on the science-policy interaction within highly topical conservation and management issues. …

SDOO
Abrupt warming episodes punctuate Greenland ice core records throughout the last glacial period. These events were first identified in two Greenland stable water isotope records (Dansgaard et al., 1993), and …

SEANA
Global shipping is undergoing significant changes. In January 2020 the maximum sulphur emission by ships in international waters will reduce from 3.5% to 0.5% by mass, as a result of …

Seismic investigation of a subglacial lake
Field Team includes: Alex Brisbourne (BAS), Andrés Rivera (CECs), Rodrigo Zamora (CECs), Field Guide (BAS). Antarctic subglacial lakes contain unique records of ice sheet history and microbial life; they may …

SiCLING
The polar regions are experiencing the most rapid climate change observed on Earth: temperatures are rising in some regions of the Arctic and Antarctic at more than double the global …

SIOS
Svalbard Integrated Earth Observing System (SIOS) is an international infrastructure project. There are 26 partners from Europe and Asia involved. The essential objective is to establish better coordinated services for …

SIWHA
The NERC funded SIWHA_CO2 project “Sea Ice and Westerly winds during the Holocene in coastal Antarctica, to better constrain oceanic CO2 uptake” will be a breakthrough in our understanding of how …

Skeleton structure, size, predation and climate change
How do the skeletons of marine animals change with habitat and environmental conditions? External skeletons, in the form of calcium carbonate shells are found predominantly in molluscs and brachiopods (marine …

Skua monitoring at Rothera
The small population of south polar skuas (up to 25 pairs) at Rothera Point has been studied since the late 1990s. The initial intention was to monitor possible impacts of …

Snow Hill Emperor Penguin Expedition
A BAS science team has returned from Snow Hill emperor penguin colony, where they have conducted survey work, collected guano samples for DNA analysis and deployed the first tracking tags …

SO-AntEco
The South Orkney Islands is a small archipelago located in the Southern Ocean, 375 miles north-east of the tip of the Antarctic Peninsula. The seafloor around the South Orkney Islands …

SO-CHIC
The Southern Ocean regulates the global climate by controlling heat and carbon exchanges between the atmosphere and the ocean. Rates of climate change on decadal time …

SO-ICE
The European Space Agency (ESA) Southern Ocean-Ice Shelf Interactions (SO-ICE) project is a collaborative research project bringing together the ESA Polar+ Ice Shelves and 4D Antarctica projects, and the European …
SO-WISE
We are constructing observationally-constrained estimates of the state of the Weddell Gyre, including associated ice shelves and sea ice Introduction In the 25 years between 1992 and 2017, ocean melting …

SONA
The Southern Ocean Network of Acoustics (SONA) represents a group of scientific institutes and industrial partners who have united to measure an under-sampled component of the ecosystem – the mid-trophic …

SONATA
The Southern Ocean is one of the most important and poorly understood components of the global carbon cycle that profoundly shapes Earth’s climate. It is the primary hot spot for …

SORBS
Violent eruptions on the Sun can trigger large magnetic storms at the Earth lasting for days. These storms can increase the number of high-energy charged particles trapped in the radiation …

South Georgia GIS
Visualise and download topographic, management and scientific data for South Georgia.

South Georgia Lost Giants
South Georgia’s Lost Giants is part of the British Antarctic Survey’s “Wild Water Whales” project studying the recovery of whales from historical exploitation in South Georgia. Antarctic blue whales (Balaena …

South Georgia Pelagic Biodiversity
The South Georgia Pelagic Biodiversity project is a Darwin-funded project, led by BAS, and in partnership with the Government of South Georgia and the South Sandwich Islands (GSGSSI) and the …

South Georgia Right Whale project
Long term surveys of the recovery of whales from historical exploitation in South Georgia waters are carried out by the British Antarctic Survey’s “Wild Water Whales” project. At present the …

South Georgia seabirds from space
Globally-important populations of seabirds breed at South Georgia. However, human-induced impacts have led to the decline of many seabird populations. Four species of albatrosses and white-chinned petrels have shown persistent …

SPACESTORM
SPACESTORM is a collaborative project to model space weather events and find ways to mitigate their effects on satellites. Over the last ten years the number of satellites on orbit …

Spatial Segregation of Seabirds at South Georgia
Seabirds are amongst the most globally threatened birds, often as a consequence of incidental mortality (bycatch) in fisheries [1] [2]. At South Georgia, wandering albatrosses have declined since the 1970s [3], and are listed …

Stability and Instability – Records of External Drivers and Resulting Behaviour of Thwaites Glacier
THOR is a ship-based and ice-based project that will examine sedimentary record both offshore from the glacier and beneath the ice shelf, together with glacial landforms on the sea bed, …

SubICE
The Sub-Antarctic – ice coring expedition (SubICE), part of the international Antarctic Circumnavigation Expedition (ACE), successfully drilled several shallow ice cores, from five of the remote and globally significant sub-Antarctic …

SuperDARN
The Super Dual Auroral Radar Network (SuperDARN) has been operating as an international co-operative organisation for over 25 years, and has proved to be one of the most successful tools …

Sustainability
The Antarctic Infrastructure Modernisation Programme (AIMP) Sustainability Strategy comprises eight major sustainability themes.

Sustained Monitoring of Whales at South Georgia
It is now estimated that >30,000 whales visit South Georgia in summer, making this sub-Antarctic island the highest-density UK hotspot for recovering whales, including critically endangered Antarctic blue whales. The …

SWESNET
The British Antarctic Survey (BAS) provides a forecast of high energy electrons in the Earth’s radiation belts which can cause damage to satellites on orbit. These forecasts are used by …

SWIGS
Certain ground based technologies, such as electrical power grids, pipelines and railways are susceptible to the effects of Space Weather. Changes in the way the magnetic fields of the …

TEA-COSI
TEA_COSI assesses Arctic Sea-ice which has an important impact on currents and ocean circulations around the globe

Testing space flight missions at Halley
The remoteness and winter isolation of communities working in Antarctica provide an excellent environment for research into human behaviour, performance, health and well being. Many studies of overwintering staff in Antarctica …

The effects of long-term changes in the Earth’s magnetic field
The Earth’s magnetic field plays a key role in the interaction between the solar wind and near-Earth space, which affects the upper atmosphere (~100-500 km altitude) in particular in the …

The evolution and ecology of Antarctic sea floor communities
The evolution and ecology of Antarctic sea floor communities is a UKRI Future Leaders Fellowship, led by Dr Rowan Whittle, looking at the past, present and future of life at …

The Global Electric Circuit
Weather and climate prediction are inevitably limited by incomplete knowledge of the Earth system and its external influences. One under-explored and consequently controversial area of research is the meteorological influence …

The Heated Settlement Panels
How will life and biodiversity on Earth will respond to climate change? This information is particularly urgent for the waters along the Antarctic Peninsula, which are experiencing rapid regional climate …

The role of Antarctic sea-ice in global climate
Sea-ice is frequently cited as a likely driver and propagator of abrupt climate change because of the rapid and far-reaching impact of its feedbacks. However, numerical climate models are still …

The role of the Southern Ocean in regulating atmospheric CO2 on glacial-interglacial timescales
The cause of the variability in atmospheric CO2 over glacial-interglacial timescales has been a puzzle since its discovery in the early 1980s. It is widely believed to be related to …

The Sustainable Flag Project
Flags which are crucial in denoting safe travel, visual aids to relocate deep field scientific instruments and marking station equipment are constantly shedding polyester Microplastics across Antarctica. This is particularly …

THeMES
The thermosphere is the uppermost layer of our atmosphere at the edge of space (85 to 1000 km altitude). Within this region orbit thousands of satellites worth billions of pounds …

UKESM-BAS
Reliable projections of the Earth’s climate are at the heart of scientific support for international efforts to address global change. There is increasing recognition that reliable projections require that physical …
Using an Antarctic fungus as a wintertime biopesticide
Can a fungus from an Antarctic soil be used to control weevil larvae causing damage to UK soft fruits and forestry? The larvae of weevils, which overwinter in soil and …

WAMSISE
WAMSISE is a three-year project starting in November 2018 and funded through a Marie Skłodowska-Curie Action (MSCA) Global Fellowship (H2020-MSCA-IF-GF-2017 no.: 792773 WAMSISE). The evolution of the Antarctic Ice Sheet …

Water isotopes in UKESM2
We will add water tracers (including stable water isotopes) to the UK Earth System Model (UKESM2) which will track through the model’s hydrological cycle. This work started under the EU …

Water Resources of the Upper Indus Basin
The Indus River Basin feeds the world’s largest system of irrigated agriculture, supporting over 300 million people across India and Pakistan. Demand on freshwater in this region is growing, and …

Weddell Sea ice sheet and climate
In the south of the Weddell Sea lies the Ronne and Filchner Ice Shelves. During the coldest part of the last glacial period about 25,000 years ago, the ice in …

West Antarctica wind strength and atmospheric circulation
Changes in wind strength and circulation patterns above the Antarctic Peninsula are linked to its warming and increased upwelling of warm circumpolar deep water, resulting in accelerated melting and thinning …

White-chinned Petrel Tracking
The white-chinned petrel is the most common bird species recorded as fisheries bycatch in the Southern Ocean [1]. Although currently listed as Vulnerable by the IUCN, limited population trend data …

Whole Atmosphere Climate Change
The near-Earth space environment is host to an increasing amount of advanced, satellite-based technology, used for both commercial and scientific purposes. To safeguard this technology and ensure that we can …

Wildlife from Space
Many populations of wildlife are remote, inaccessible or difficult to monitor. The advent of sub-metre, Very-High-Resolution (VHR) satellite imagery may enable us study these animals in a much more efficient …

Winter Krill at South Georgia
The Winter Krill project is a Darwin Plus project, funded by Defra, and its activities are focussed on South Georgia (SG), which is part of the UK Overseas Territory (OT) …

WISE-ISODYN
The WISE-ISODYN (WISE: WIlkes Basin/Transantarctic Mountains System Exploration; ISODYN: Icehouse Earth: Stability Or DYNamism?) science programme was joint UK-Italian project between the British Antarctic Survey and the Italian Programma Nazionale …

WWWARP
Sub-Antarctic South Georgia island is a really important feeding ground for whales: it was at the epicentre of commercial whaling in the early 20th century, with over 170,000 whales killed …

Zavodovski Expedition
The South Sandwich Islands are the most remote and inhospitable part of the UK Overseas Territories, which means they’re also the most data-deficient. Zavodovski Island is the …

Air Infrastructure
The Rothera Air Infrastructure project is part of the Antarctic Infrastructure Modernisation Programme (AIMP) future phases. The Dash 7 aircraft is due to be phased out and the British Antarctic …




















